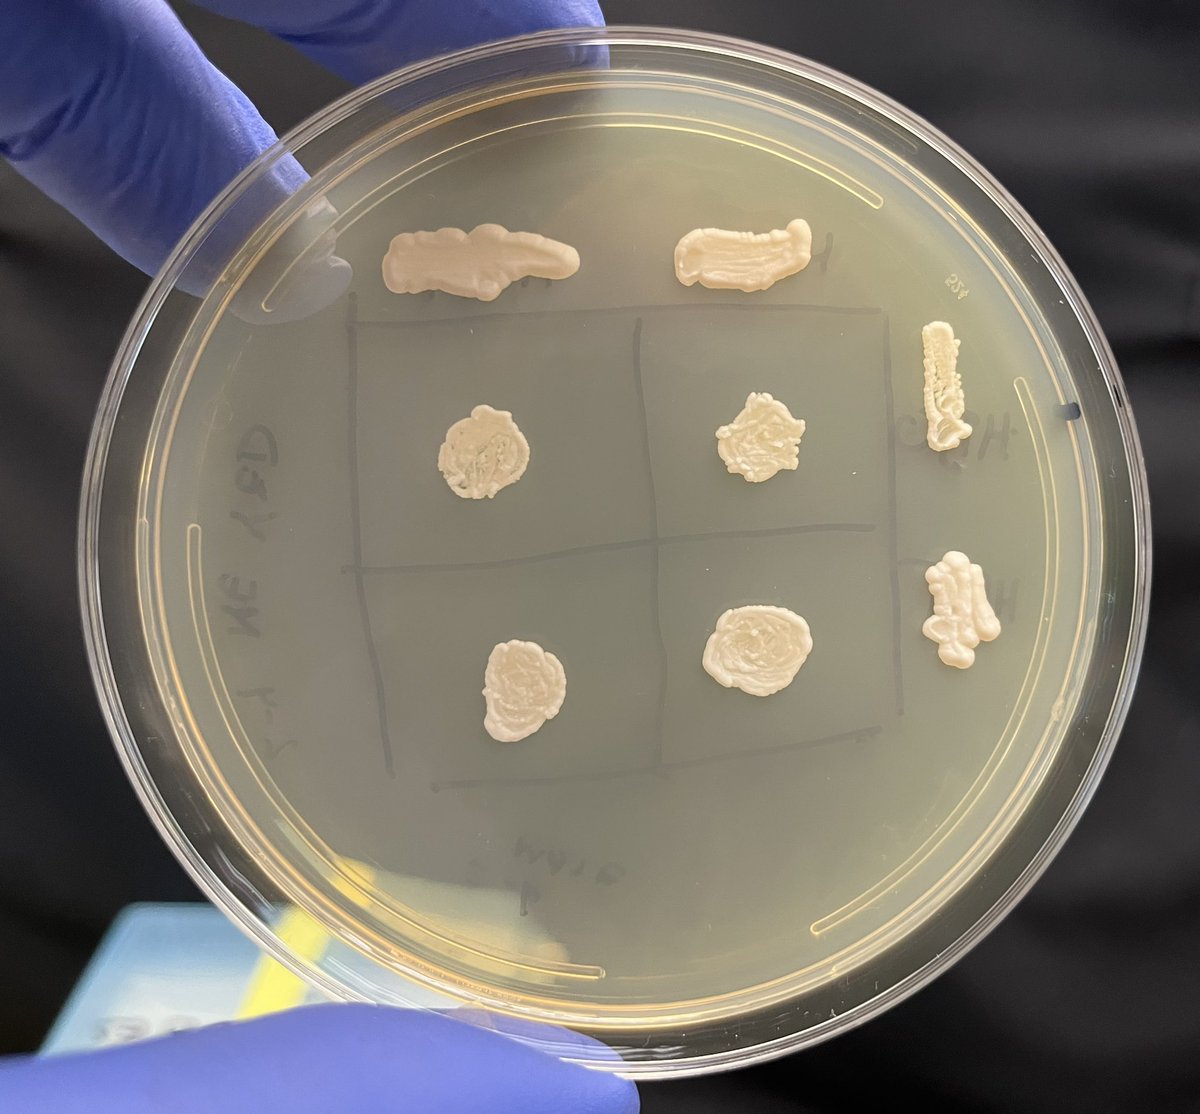
Yeast genetics. Using adenine and tryptophan mutants to explore life cycle and genetic complementation.
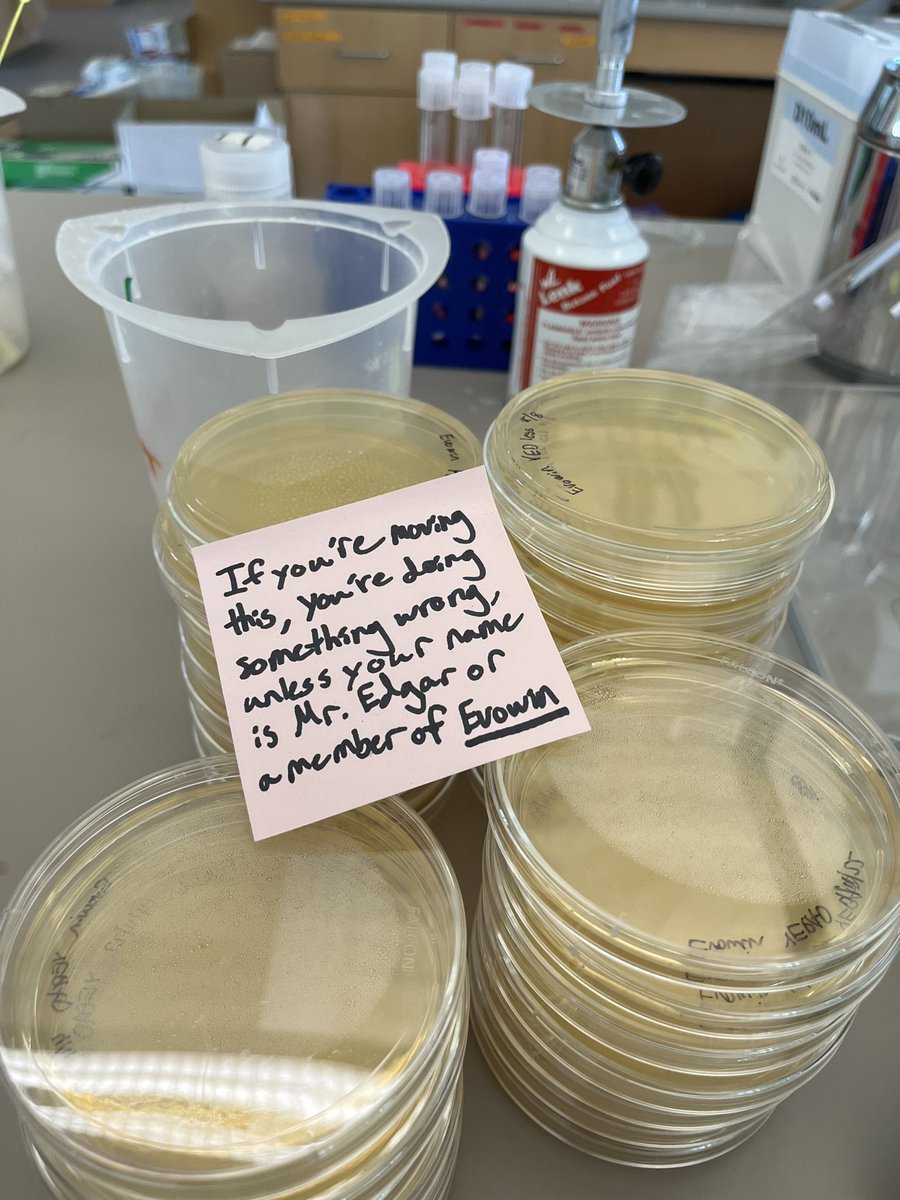
Things get serious during independent lab project time.
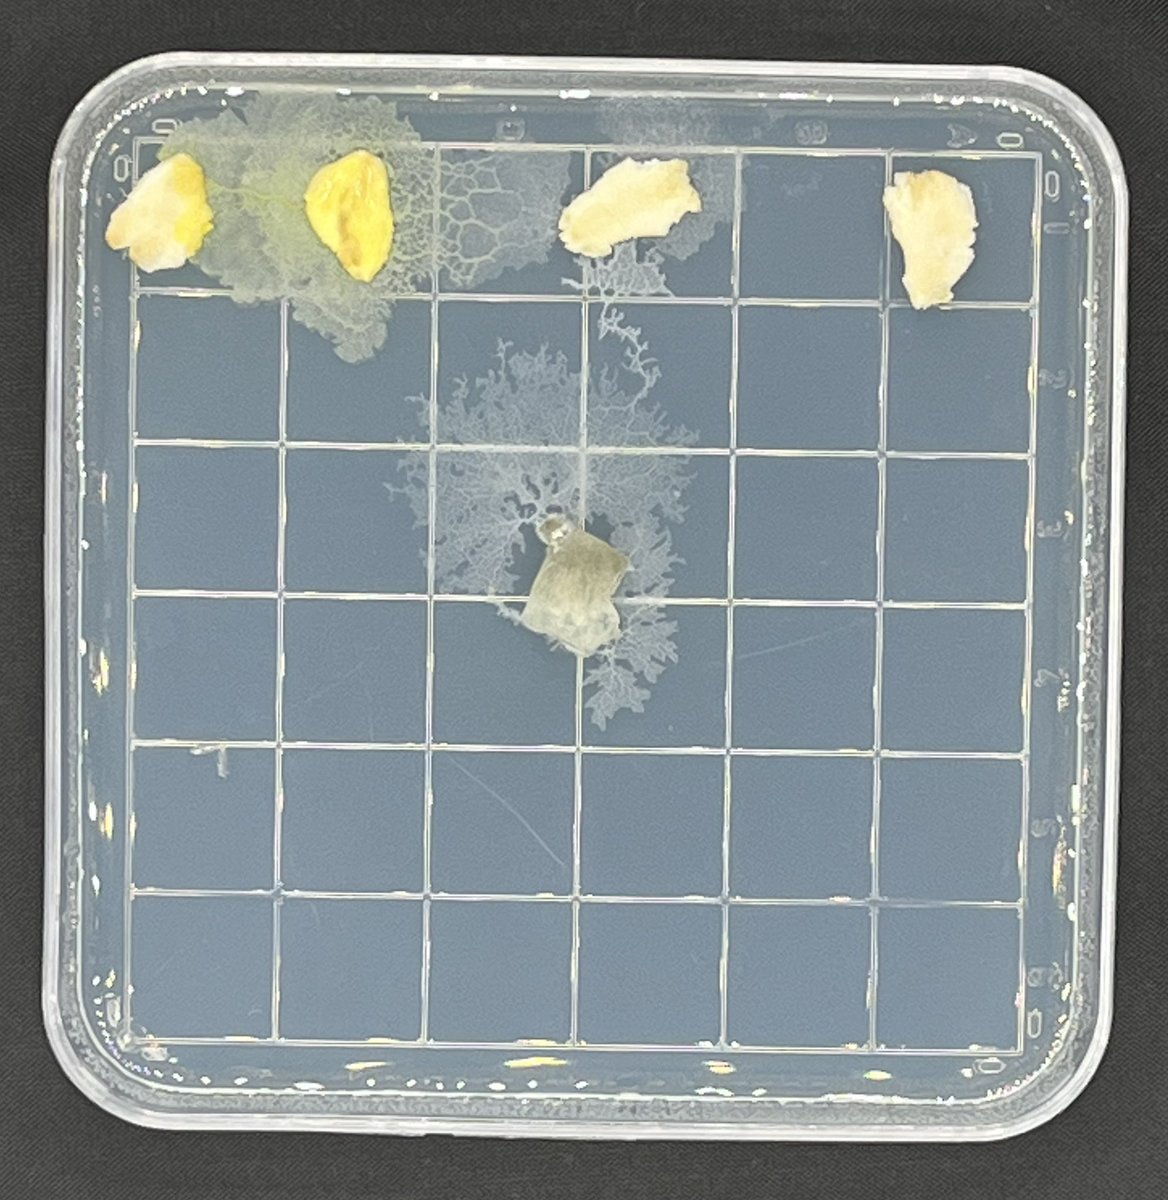
Physarum chemotaxis lab in Honors Biology. First time we have tried it in this class, looking forward to the labs they will deign

medgar9
@medgar9
Teach Biology and Molecular Genetics at Milton Academy.
ID: 17953198
08-12-2008 02:05:13
195 Tweet
87 Followers
747 Following


Got my Dino and my M&M’s from Genesee Scientific when I received my worm picks. Sort of random, but greatly appreciated. Dino lives in lab now, M&M’s don’t (they are gone).




Prep coming to a close for my first spin with EvolvingSTEM curriculum this week. Looking forward to it. Results to follow.





Happy DNA Day! Thanks to miniPCR bio we got some good results on the DFR gene in fast plants.


Media day for summer curriculum work. Working out some things for next year. EvolvingSTEM





emerginginvestigators.org/articles/incre…. Proud of these students and very thankful to Journal of Emerging Investigators for the opportunity they give our students.



Nice results across the board from miniPCR bio Chopped in vitro CRISPR lab. A good way to start my discussion.




I want to spread some love to a fellow Washington Commanders fans. I'm giving away this package i got from the 2024 NFL draft. I'll randomly pick someone that: ✅️Like ✅️Shares ✅️ Follows Hogfarmers Charitable Foundation. ❤️🎗 If you already follow, you're one step closer. #RaiseHail